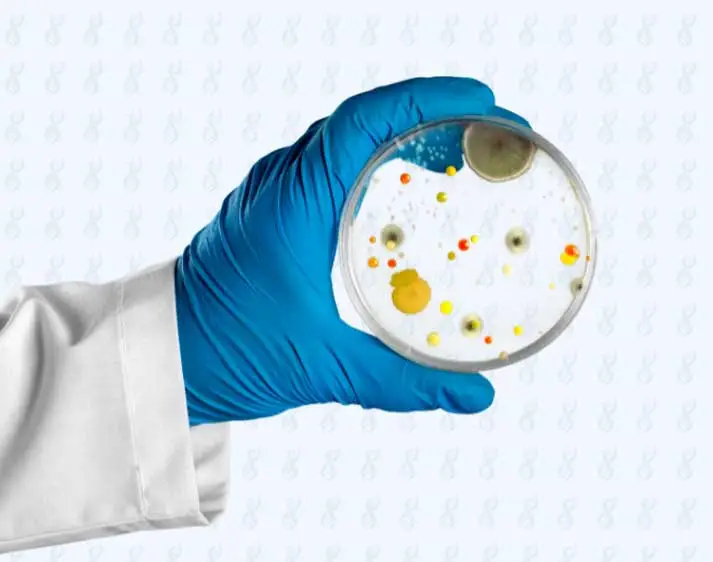
Hand in Gummihandschuh hält Petrischale mit Bakterien hoch

ARIANA ACADEMY - Ihre Plattform für Webinare und E-Learnings
Wir bieten professionelle Schulungen im Lebensmittelhandwerk, der Gastronomie und der Lebensmittelindustrie an. Dabei behandeln wir unter anderem die Themen Lebensmittelsicherheit, Lebensmittelhygiene und HACCP.

E-Learningkurse

Folgebelehrung IfSG gemäß § 43, Absatz 4
Die Folgebelehrung nach dem Infektionsschutzgesetz ist alle zwei Jahre Pflicht und betrifft alle Personen, die gewerbsmäßig bestimmte Lebensmittel herstellen, behandeln oder in den Verkehr bringen.
- E-Learning
- 20 Minuten
- 17,50 € netto (20,83 € brutto)

Folgebelehrung IfSG gemäß § 43, Absatz 4 und Personalhygiene
Die Folgebelehrung nach dem Infektionsschutzgesetz ist alle zwei Jahre Pflicht und betrifft alle Personen, die gewerbsmäßig bestimmte Lebensmittel herstellen, behandeln oder in den Verkehr bringen.
- E-Learning
- 30 Minuten
- 25 € netto (29,75 € brutto)

HACCP Schulung gemäß VO (EG) Nr. 852/2004
Das Basisseminar für alle, die sich neu mit dem Thema HACCP auseinandersetzen oder eine kurze Auffrischung des Grundwissens benötigen.
- E-Learning
- 90 Minuten
- 50 € netto (59,50 € brutto)

Reinigung und Desinfektion gemäß VO (EG) Nr. 852/2004
Das Basisseminar für alle, die sich neu mit dem Thema Reinigung und Desinfektion auseinandersetzen oder eine kurze Auffrischung des Grundwissens benötigen.
- E-Learning
- 30 Minuten
- 25 € netto (29,75 € brutto)

Schädlingsbekämpfung gemäß VO (EG) Nr. 852/2004
Das Basisseminar für alle, die sich neu mit dem Thema Schädlingsbekämpfung auseinandersetzen oder eine kurze Auffrischung des Grundwissens benötigen.
- E-Learning
- 30 Minuten
- 25 € netto (29,75 € brutto)

Umfeldprobenahme mittels Abklatsch
Das Basisseminar für alle, die den korrekten Umgang mit Abklatschproben erlernen möchten.
- E-Learning
- 20 Minuten
- 20 € netto (23,80 € brutto)

Umfeldprobenahme mittels Schwammproben
Das Basisseminar für alle, die den korrekten Umgang mit Schwammproben erlernen möchten.
- E-Learning
- 20 Minuten
- 20 € netto (23,80 € brutto)

Umfeldprobenahme: Tupfer
Das Basisseminar für alle, die den korrekten Umgang mit Tupferproben erlernen möchten.
- E-Learning
- 20 Minuten
- 20 € netto (23,80 € brutto)

Umfeldprobenahme: Luftkeimmessung mittels Impaktion
Das Basisseminar für alle, die das Verfahren der Impaktion und die korrekte Durchführung der Luftkeimmessung kennen lernen und erlernen möchten.
- E-Learning
- 20 Minuten
- 20 € netto (23,80 € brutto)
Umfeldprobenahme: Luftkeimmessung von Luft und Druckluft
Schulung zur Luftkeimmessung mittels Impaktion mit dem IEH Air Sampler
- E-Learning
- 30 Minuten
- 25 € netto (29,75 € brutto)

Entnahme von betriebsinternen Trinkwasserproben
Schulung gemäß Trinkwasserverordnung und QS Leitfaden für alle, die betriebsinterne Trinkwasserproben ziehen.
- E-Learning
- 25 Minuten
- 25 € netto (29,75 € brutto)

Fachkenntnisse in der Lebensmittelhygiene – Modul 1: Schulung nach Hygienerecht und IfSG (gemäß § 43, Absatz 4)
Schulung gem. § 4 LMHV und Anhang II Kapitel XII Nr. 1 der VO (EG) Nr. 852/2004
- E-Learning
- 70 Minuten
- 40 € netto (47,60 € brutto)

Fachkenntnisse in der Lebensmittelhygiene – Modul 2: Fleisch
Schulung gem. § 4 LMHV und Anhang II Kapitel XII Nr. 1 der VO (EG) Nr. 852/2004
- E-Learning
- 40 Minuten
- 30 € netto (35,70 € brutto)

Fachkenntnisse in der Lebensmittelhygiene - Modul 3: Fisch
Schulung gem. § 4 LMHV und Anhang II Kapitel XII Nr. 1 der VO (EG) Nr. 852/2004
- E-Learning
- 30 Minuten
- 25 € netto (29,75 € brutto)

Fachkenntnisse in der Lebensmittelhygiene - Modul 4: Milch und Käse
Schulung gem. § 4 LMHV und Anhang II Kapitel XII Nr. 1 der VO (EG) Nr. 852/2004
- E-Learning
- 90 Minuten
- 50 € netto (59,50 € brutto)

Fachkenntnisse in der Lebensmittelhygiene - Modul 5: Obst und Gemüse
Schulung gem. § 4 LMHV und Anhang II Kapitel XII Nr. 1 der VO (EG) Nr. 852/2004
- E-Learning
- 15 Minuten
- 15 € netto (17,85 € brutto)

Fachkenntnisse in der Lebensmittelhygiene - Modul 6: Gastronomie
Schulung gem. § 4 LMHV und Anhang II Kapitel XII Nr. 1 der VO (EG) Nr. 852/2004
- E-Learning
- 30 Minuten
- 25 € netto (29,75 € brutto)

Basiswissen LMIV – Kennzeichnungselemente bei vorverpackten Lebensmitteln Teil 1
Dieses Seminar vermittelt die Basiskenntnisse zur Kennzeichnung von vorverpackten Lebensmitteln.
- E-Learning
- 70 Minuten
- 40 € netto (47,60 € brutto)

Basiswissen LMIV – Kennzeichnungselemente bei vorverpackten Lebensmitteln Teil 2
Dieses Seminar vermittelt die Basiskenntnisse zur Kennzeichnung von vorverpackten Lebensmitteln.
- E-Learning
- 60 Minuten
- 40 € netto (47,60 € brutto)

Basiswissen LMIV – Besondere Kennzeichnungsvorschriften
Dieses Seminar vermittelt die Basiskenntnisse zur Kennzeichnung von vorverpackten Lebensmitteln.
- E-Learning: Video
- 35 Minuten
- 30 € netto (35,70 € brutto)

Video: Folgebelehrung gemäß § 43 Abs. 1 IfSG von Lebensmittelunternehmen
Die Folgebelehrung nach dem Infektionsschutzgesetz ist alle zwei Jahre Pflicht und betrifft alle Personen, die gewerbsmäßig bestimmte Lebensmittel herstellen, behandeln oder in den Verkehr bringen.
- E-Learning: Video
- 45 Minuten
- 45 € netto (53,55 € brutto)

Video: Temperatur-anforderungen in der Lebensmittelproduktion
Für alle Berufsgruppen, die mit der Lagerung und Zubereitung von Lebensmitteln zu tun haben.
- E-Learning: Video
- 20 Minuten
- 20 € netto (23,80 € brutto)
Kurzschulungen

Allgemeine Einführung in das Kundeninformationssystem (KIS)
Diese kostenlose Schulung richtet sich an alle Kunden der Ariana Labore, die eine allgemeine Einführung in das neue Kundeninformationssystem (KIS) benötigen.
- E-Learning
- 40 Minuten
- kostenlos

HACCP & Allgemeine Grundsätze zur Lebensmittelhygiene
Diese kostenlose Kurzschulung vermittelt die wichtigsten Grundlagen zu HACCP und den allgemeinen Grundsätzen der Lebensmittelhygiene.
- E-Learning
- 15-20 Minuten
- kostenlos

Was Sie über Listerien wissen sollten
Diese kostenlose Kurzschulung vermittelt die wichtigsten Grundlagen über Listerien in Lebensmittelbetrieben.
- E-Learning
- 10-15 Minuten
- kostenlos

Einführung ins Allergenmanagement
Diese kostenlose Kurzschulung richtet sich an alle Mitarbeitenden, die eine Einführung in das Allergenmanagement benötigen.
- E-Learning
- 15 Minuten
- kostenlos

Entnahme von Umfeldproben (Schwammtupfer mit Stiel)
In dieser kostenlosen Kurzschulung wird anhand eines Schwammtupfers mit Stiel gezeigt, wie die korrekte Entnahme von Umfeldproben durchgeführt wird.
- E-Learning
- 5 Minuten
- kostenlos

Händewaschen und Mitarbeiterhygiene
Diese kostenlose Kurzschulung vermittelt die wichtigsten Grundlagen zum richtigen Händewaschen und zur Mitarbeiterhygiene.
- E-Learning
- 10 Minuten
- kostenlos
Webinare und Seminare

Fachkenntnisse in der Lebensmittelhygiene gemäß § 4 LMHV und Anhang II Kapitel XII Nr. 1 der VO (EG) Nr. 852/2004
Im Rahmen dieses Seminars werden Fachkenntnisse zum Umgang mit Lebensmitteln und in der Lebensmittelhygiene vermittelt.
- Webinar (via MS Teams)
- 4 Studen
- 350 € netto (416,50 € brutto)

Fremdkörperdetektion
Erfahren Sie, wie Sie Fremdkörper effektiv erkennen und Risiken minimieren – ein Seminar für Qualitäts-management und Instandhaltung in der Lebensmittelbranche.
- Webinar (via MS Teams)
- 4 Studen
- 350 € netto (416,50 € brutto)

Grundlagen Lebensmittelrecht / HACCP
Das Basisseminar für alle, die sich neu mit dem Thema HACCP und betriebliche Eigenkontrollen auseinandersetzen oder eine kurze Auffrischung des Grundwissens benötigen.
- Webinar (via MS Teams)
- 4 Studen
- 350 € netto (416,50 € brutto)

Kennzeichnung von vorverpackten Lebensmitteln – Basiswissen Verordnung (EU) Nr. 1169/2011 (LMIV)
Dieses Seminar richtet sich an Lebensmittelunternehmer und HACCP-Beauftragte, die Lebensmittel herstellen und die Basiskenntnisse zur Kennzeichnung von vorverpackten Lebensmitteln erwerben möchten.
- Webinar (via MS Teams)
- 4 Studen
- 350 € netto (416,50 € brutto)

Seminar: Interner Auditor
Dieses Seminar eignet sich für Mitarbeiter aus Unternehmen der Lebensmittelbranche, die die Aufgabe haben, Bereiche des Qualitätsmanagementsystems intern zu auditieren und/oder Lieferantenaudits durchzuführen.
- Seminar
- 7 Studen
- 700 € netto (833 € brutto)

Webinar: Fit für die Eissaison
Dieses kostenlose Online-Seminar richtet sich speziell an Eiscafés und Eisdielen.
- Webinar (via MS Teams)
- 2 Studen
- kostenlos
Sense Case

Sense Case – Sensorikschulung gemäß DIN EN ISO 8586:2023
Das Sense Case ist ein Trainingskoffer, mit dem Sie Ihre Mitarbeiter:innen für alle Sinne fit machen.
- E-Learning inkl. Schulungs-equipment
- Vorbereitungszeit: 1,5 Std. (Durchführung Tests: 30 Min.)
- 250 € netto (297,50 € brutto) Für 20 Prüfer und eine Leihgabe von 4 Wochen
Nichts Passendes gefunden?
Wir bieten maßgeschneiderte Schulungen –
exakt auf Ihre Anforderungen zugeschnitten.